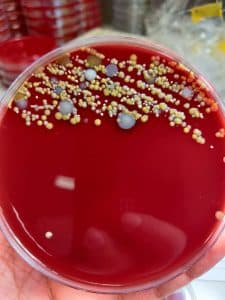

It’s important to note that more than 3,000 experiments have been conducted aboard the International Space Station during the 21 years humans have been living and working in space.
These experiments have provided insights helping improve life back on Earth and explorations farther into the solar system. Also Chinese scientists reported that they have conducted a first-of-its-kind experiment to produce blood stem cells in space.
The stem cells were brought back to Earth by the Shenzhou 15 spacecraft after being cultured for half a month in the Wentian lab module of China’s Tiangong space station.
Space microbiology

has been on the rise since the 1960s and particularly with Russia leading the way to space during the cold war based on the orbital exploration of Cosmonaut Yuri Gagarin for the ROSCOSMOS.
With increasing know-how in Astrology, for those who may know, HeLa cells, which are cells collected from Henrietta Lacks at the Johns Hopkins University medical hospital, before her death were sent on the Soviet satellite Sputnik-6 to understand human space missions deemed at determining the long term effects of space travel on living cells and tissues.
Scientists discovered that HeLa cells divide more quickly in zero gravity. Elon Musk’s SpaceX is working on its own space breakthroughs as well.
In blazing an avant-garde trail in Astrobiology, built on the foundations of the above aerospace/space organisations and space research milestones, SpaceoMix and SOAD have forged a collaboration to build a cutting-edge research and development laboratory on the lunar surface to drive a new height in human, nano and cellular experimentation.
The work by SpaceoMix will no doubt signpost a new paradigm in innovation, education and scientific advancement. One of several goals of SpaceoMix and SOAD in this union of historic makings is to stimulate a thriving space industrial complex on the African continent, inspiring new frontiership of ideas amongst the youthful population and pushing an entrepreneurship drive for the successor generations to look beyond terra firma and aspire to microgravity driven possibility for holistic economic growth, scientific imperatives and human proliferation that will give rise to new knowledge and competitiveness for the black continent. This view has also has been affirmed by His Excellency Dr. Louis-Georges Tin, Prime Minister of SOAD and Ambassador Chev Anthony of SOAD Malta Diplomatic Mission who worked tirelessly to make this collaboration possible with SpaceoMix founder Mr. Borg. SOAD Ministry of Trade, Chief-of-Staff Ambassador Uchenna Ezeokeke, a medical radiology professional practising in Dublin, expressed “this feat between SpaceoMix and SOAD is watershed moment for Space odyssey”, same as Eric Masaba, CEO of Texxi, Jay Rosborough of Affiliated Group and Joshua Olamide Benjamin, a Space Physicist and PhD candidate feel about the laudable project.

From my childhood aspirations to become an astronaut to my later years promoting the defuncted Mars One project envisioned by Bas Lansdorp, it had remained my goal to push the African business community and governments to look spaceward.
In this chat with SpaceoMix Chief Executive, Mr. Borg, he tells me what the journey to the lunar surface to sequencing DNA is all about, raising the much needed funds for the project, why this project is an important asset to Africa, what the educational and innovation benchmarks are currently and can be in the future.
The Prime Minister of SOAD, Dr. Louis-Georges Tin expressed that he is using the opportunity of this unique frontier space mission to invite Nigeria as Africa’s largest black population to come on board the SOAD-Spaceomix collaboration, leading the way for other African nations and their business communities and governments to follow in making this scientific investment leave a dent on humanity: Do enjoy the interview.
1. Congratulations on signing the Spaceomix collaboration with SOAD.
Thank you! The collaboration with SOAD is a significant step toward pushing the boundaries of space exploration and science.
2. Can you tell our audience more about the technology behind the Spaceomix developed and proprietary new generation set of LunarXCube payloads?
Certainly! The LunarXCube is a cutting-edge technology designed for space bioscience missions. It’s a compact, next-gen payload system enabling real-time cell biology studies, DNA sequencing, and analysis of the effects of space conditions on biological systems. This includes sample handling via specialized wells and a lab-on-a-chip approach for precise DNA analysis.
3. DNA Sequencing in space is definitely stretching the boundaries of Astrobiology. What in the long term do you seek to achieve with your experiments and results of your work?
Our goal is to understand how space conditions impact biological systems at a molecular and genetic level. By studying these effects in real time on the lunar surface, on the ISS, and in ground control analogs, we aim to gain insights into adapting life for prolonged space missions and possibly uncovering new medical applications for Earth.
4. Nanobiology is a new discipline with the potential to revolutionize medicine. Are you applying any rare nanobiological procedures on your team?
Our team is exploring the possible fusion of nanoscience and biology. We intend to use nanotechnology to address biological challenges, potentially leading to innovative medical solutions. This includes devising molecular devices using biomaterials and nanoscience tools for our research.
5. Could the outcomes of DNA sequencing on the lunar surface breach ethical principles?
We’re committed to ethical research practices. Our focus is on advancing scientific knowledge while adhering to stringent ethical standards in space exploration and biological research.
6. Is synthetic biology a part of your current or future work?
Synthetic biology holds great promise for our research. While we’re not directly applying it at this stage, we see potential future applications in fabricating functional materials and exploring new methods for biological adaptation in space.
7. Do you foresee AI impacting your work on the lunar surface?
Absolutely. AI plays a vital role in data analysis and decision-making processes. It can enhance our ability to interpret complex biological data collected from space missions, enabling more efficient and insightful research.
8. Why did Spaceomix embark on this scientific pursuit, considering Malta is relatively new to this field?
Spaceomix was born from a vision to push scientific boundaries. While Malta might be small and new in this specific field, our commitment to innovation and collaboration drives us to explore new frontiers in space science. May I also remind that my research team at the University of Malta has led three consecutive missions to the ISS already between 2021 and 2023.
9. What is your academic background?
My academic journey includes a first degree in Applied Biomedical Science,
Followed by MSc in Molecular Genetics and PhD in Genetics from the University of Malta. I also form part of both ESA’s space omics topical teams and NASA’s Gene Lab analysis working groups.
10. Does Spaceomix seek to advance Kathleen Rubins’ achievements in DNA sequencing in space?
Absolutely, we aim to build upon Rubins’ pioneering work by furthering the scope and depth of DNA sequencing in space through our unique approaches and technologies.
11. Is part of SpaceoMix’s work aimed at finding nanoengineered preventive or repair processes at the DNA level due to radiation exposure?
Research into nanoengineered solutions to counter genetic alterations caused by radiation exposure is an important aspect of our work. We strive to explore potential preventive or repair mechanisms at the DNA level.
12. Does SpaceoMix aim to study aging and its reversal in microgravity or deep space?
While aging and its reversal are complex phenomena, our research may contribute to understanding how space conditions impact biological aging processes. However, direct reversal studies are not currently part of our focus.
13. How is SpaceoMix involving African academia in its pursuits? We’re actively engaging with African academia through educational programs, collaborations, and sharing our findings. We aim to foster knowledge exchange and inspire the next generation of African scientists in space exploration.
14. Does your experimental work involve the use of HeLa cells?
While HeLa cells are valuable for various research, we’re exploring a range of cell types and models to comprehensively understand the effects of space conditions on diverse biological systems.
15. Other important outcomes SpaceoMix seeks to achieve?
Besides advancing space bioscience, we aim to inspire global scientific collaboration, contribute to medical advancements, and foster a deeper understanding of life’s adaptability in extreme environments.
16. Why should the global investor community fund SpaceoMix’s $10 million project?
Investing in SpaceoMix means supporting groundbreaking research that expands humanity’s understanding of space biology and its potential applications in medicine. This investment could pave the way for revolutionary advancements benefiting both space exploration and healthcare on Earth.
Thanking SpaceoMix and SOAD for their remarkable trailblazing efforts in space exploration.
Thank you! We’re excited about the possibilities and grateful for the support in our mission to explore the frontiers of space science and biology. 🧬



















